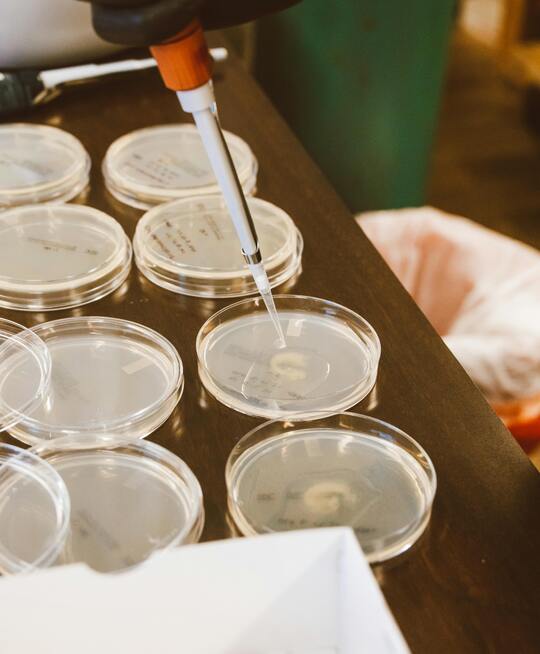
about-bg-img

HYAR is not just a company; it's a journey fueled by a passion for innovation, sustainability, and a commitment to making a positive impact in food, culture media, pharmaceuticals and biotechnology. Our story began with a vision to revolutionize these industries, and over the years, we have evolved into a pioneering force, continuously pushing the boundaries of what's possible.